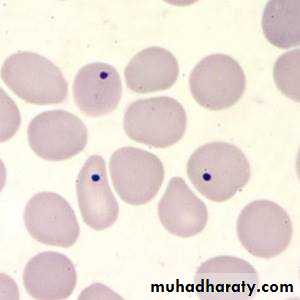

ANEMIA
Defined as decrease in the amount of red blood cells ( RBC) OR in the amount of hemoglobin ( Hb) in the blood , so there will be lowered ability of the blood to carry O2 to the tissues .In order to define anemia you have to know what is the normal values of hemoglobin ( according to the sex ) !
Male 13 - 18 g/dl ( 130 -180 g/l )
Female 11.5 – 16.5 g/dl ( 115 – 165 g/l)Hematocrit (HCT) = Hb * 3
Anemia itself is not a diagnosis !!
It is a sign of many underlying diseases .. i.e , you should look for the cause of anemia ..Causes :
Anemia generally caused by the following mechanisms :1.Blood loss ( trauma , surgery , GIT bleeding , GUT bleeding , menorrhagia …etc)
2. Inadequate RBC producation ( iron difficiency anemia, vitamin B 12 difficiency , folic acid difficiency , anemia of chronic diseases )3. RBC destruction ( hemolysis, which is either caused by intrinsic causes like defect in the hemoglobin chain e.g thalasemia, defect in the membrane e.g spherocytosis , or defect in the enzymes e.g G6PD difficiency ,, or caused by extrinsic factors like infection & drugs.
What is mean corpuscular volume ( MCV ) ? Significance ?
MCV reflects erythrocyte size , its normal range 78 – 98flUnderstanding the MCV can guide the doctors to charactarize certain anemia .. How ?!
MCV below 78 fl called microcytic anemia
MCV 78 – 98 called normocytic anemiaMCV above 100 fl called macrocytic anemia
MCV > 100
( Macrocytic)MCV 78 – 100
( normocytic)
MCV < 78
( Microcytic)
1.B12 dificiency
2. Folic acid dificiency3. Myelodysplastic syndrome ( MDS)
4. Hypothyroidism
5. Alcohol6. Liver disease
7. Drugs ( hydroxurea , zidovudin, Methotrexate)1.Anemia of kidney diseases
2. Anemia of chronic infections3. Anemia of malignancy
4. Anemia of chronic inflammatory diseases.1.Iron dificiency anemia
( IDA)2. Thalassemia
3. Occasionally anemia of chronic diseases .
Differentiate IDA , thalassemia & anemia of chronic disease
Clinical features of anemia
SYMPTOMS :Most of the symptoms result from poor perfusion of the tissues
1.Fatigue
2. Dizziness
3.Headache
4.Blurred vision
5. Exertional dyspnoea
6.Chest pain
7.Palpitation
8. Pica ! ( IDA )( ingestion of non nutritional materials , ice , clay , papers …..)
9. Neuropathy ( B12 D-) .
SIGNS :
1. Dyspnoea !
2. Tachycardia
3.Pallor ( every anemic pt. is pale , but not every pale pt. is anemic !! ) ( conjunctiva , palmer creases & mucus membranes)
4.. Angular cheilitis (IDA)
5 . Glossitis ( B12 , IDA )
6 . Jaundice ( hemolysis , megaloblastic anemia
7. Koilonachia ( spoon nails ) ( IDA)
8 . Bruises ( bleeding tendency )
9 . Lymph node !
10. Organomegally
11. Evidence of the underlying disease ! ( features of renal disease , liver disease , malignancy , rheumatoid arthritis , SLE …..)
Glossitis
Work up !
1.Careful history : don’t forget nutritional hx. , gynecological hx in women , drugs , family hx of anemia…etc.2. Proper physical examination
3. Investigations:
a. CBC & Blood film ( Hb, HCT, MCV , MCH , MCHC , WBC & differential , platelets , reticulocytes ( will be high in hemolytic anemia & bleeding) , the blood film may show anisocytosis ( abnormality in the size of the RBC), poikilocytosis ( abnormality in the shape of RBC) ,or abnormal cells like : tear drop cells ( myelofibrosis ) , cigar shape cells ( iron difeciency anemia) , target cells ( thalasemia , liver disease ) , RBC fragments ( shistocytes ) ( in microangiopathic hemolytic anemias) , howel jolly bodies ( splenectomy ) , blister cells & bite cells ( G6PD dificiency ) , burr cells ( uremia ) … etc.
Target cells
Tear drop cells ( myelofibrosis )
Blister cells ( G6PD D-)
Bite cells ( G6PD D-)
Howel jolly bodies
Sickle cells
RBC fragments
Burr cells( right ) , cigar shape cells (lt.)
2. Iron study ( s.iron , s.ferritin, TIBC) , S.B12 , RBC folate (in case of megaloblastic anemia ) , & other investigations according to the case ! .
3. Bone marrow aspiration & biopsy ( specially in case of bi-cytopenia or pancytopenia .
Iron dificiency anemia
This occurs when there is iron loss or physiological requirements exceed absorbtion.1. Blood loss : the most common cause in men & post menopausal women is GIT bleeding ( peptic ulcer , esoph. Varices , inflammatory bowel diseases , colorectal CA…)
Other causes including severe hemoptysis , hematuria …
In women with child bearing age , menstrual blood loss is a contributing factor .
2. malabsorption: iron is actively absorbed in the upper small intestine , so it can be affected by celiac disease , another point is gastric acid required to release iron from food & helps to keep iron in the soluble ferrous state , achlorhydria in the elderly or that caused by drugs like PPI may contribute to the lack of iron availability from the diet , as may previous gastric surgery .
3. Physiological demands :
This is occur when the iron requirements exceeding its absorption , e.g. at time of rapid growth ( puberty ) & in pregnancy ( iron is diverted to the fetus & placenta ) .Investigations of IDA :
1. Investigate the cause ( bleeding , malabsorption , parasitic infection..2. s.iron ( LOW) . S.ferritin ( LOW , very specific, confirm iron dificiency) , TIBC ( HIGH ) , transferrin saturation ( iron /TIBC * 100 ) ( LOW ), Bone marrow iron store ( rarely used ) .
Management of IDA
1. Treatment of the underlying disease .2. Iron replacement therapy :
Ferrous sulphate 200 mg 3 times daily for 3-6 months is appropriate , in patient who cannot tolerate oral form due to GI side effects , parentral form is available like iron dextran or iron sucrose & more recently iron isomaltose & iron carboxymaltose ( preferred , fewer allergic reactions ).
Failure to respond to treatment may be due to non compliance , continued blood loss , malabsorption , or even another diagnosis ! .
Blood transfusion is usually not necessary unless severe anemia with angina or heart failure or cerebral hypoxia.
Megaloblastic anemia
Result from dificiency of vitamin B12 or folic acidCauses of vit. B12 dificiency :
• 1.Dietary dificiency : occur in strict vegans .
2. Gastric pathology :release of B12 from food require normal acid secretion , therefore hypochlorhydria or gastric surgery ( gastrectomy )associated with B12 dificiency .3. Pernicious anemia : autoimmune disease , charactarized by atrophic gastric mucosa , loss of parietal cells & intrinsic factor dificiency , it may be associated with other autoimmune diseases ( vetiligo , graves dis. , hashimoto thyroiditis, addison …) , the finding of anti intrinsic factor antibodies in the context of B12 D- is diagnostic of pernicious anemia , other Ab include antiparietal cell Ab ( present in over 90% of pernicious anemia , but also present in 20 % of normal females) , schilling test is no longer used .
4. Small bowel pathology : e.g , bacterial overgrowth , fish tapeworm , IBD ( crohn”s disease ) & surgery .
Causes of folic acid dificiency :
1. Diet : poor intake of vegetables.2. Malabsorption : e.g. celiac disease
3. Increase demand : e.g. pregnancy , hemolysis
4. Drugs : e.g. phenytoin , methotrexate…
Note :
Vit. B12 D- ( but NOT folic acid D- ) , is associated with neurological disease up to 40 % of cases , the main pathological finding is focal demylination affecting the spinal cord ( subacute combined degeneration of the cord ) , peripheral n. , optic nerve & cerebrum . Manifestations include peripheral parasthesia & ataxia of gait . So the most coomon presentation is sensory .Neurological finding in B12 D- :
* Peripheral n.: glove & stocking pararsthesia, loss of ankle reflexes*spinal cord : subacute combined degeneration of the cord , mainly affecting the posterior column ( vibration & position sensation )
*cerebrum : dementia , optic atrophy
*autonomic neuropathy .
Investigations ( megaloblastic anemia)
-Hb : low , sometimes severly reduced
-MCV: high , often more than 120 fl .
-WBC: norrmal or reduced
-Platelets : normal or reduced
-Reticulocytes : low
-Blood film : oval macrocyte , poikiloctosis , hypersegmented neutrophil
-Bone marrow : increased cellularity , megaloblastic changes in the erythroid series , increase iron store…
-LDH : Elevated
-homocystein elevated in both folic acid & B12 D- , methylmalonic acid elevated only in B12 D-.
- s. B12 assay
- s. folic acid , RBC folate ( accurate).
Hypersegmented neutrophil
Treatment of megaloblastic anemia
Important note :The use of folic acid alone in the treatment of megaloblastic anemia due to B12 D- my result in worsening of the neurological deficit .
VITAMINE B12
Treatment is usually by hydroxycobalamin 1000ug IM for 6 doses ( twice a week ) , followed by maintainance therapy of 1000 ug every 3 months for life .
The 1st response to treatment is increase in reticulocyte count within 5-10 days , the Hb will rise by 10 g/l every week until normalised , be ware of hypokalemia after starting treatment ! ( when u give B12 , you are building new cells , these cells will take up potassium ) .
** when there is inadequate response to treatment & there is dimorphic picture ( mixture of microcytic & macrocytic cells ) , think of concomittant iron D- anemia .
** neurological symptoms & signs my take 6-12 months to improve & sometimes the damage is permenant .
FOLIC ACID D-:
oral folic acid 5 mg daily for 3 weeks will treat acute dificiency & then 5 mg once weekly is adequate maintainance therapy .Prophylactic folic acid in pregnancy is important to prevent neural tube defect in the fetus , folic acid also given in hematological diseases associated with reduced RBC life span like hemolysis.
Recent studies stated that folic acid can reduce the risk of coronory & cerebrovascular diseases by lowering homocystein level !.
Hemolytic anemia
Hemolysis means shortening of the normal RBC lifespan ( less than 120 days) by inherited or acquired causes .Investigations indicating active hemolysis
1. Low Hb2. Increase indirect bilirubin
3. Increase LDH
4.Increase reticulocytes
5. Increase urinary urobilinogen
Features of intravascular hh :
1. Decreased haptoglobin
2. Increase methaemalbumin
3. Positive urinary hemosiderin
4. Haemoglobinuria
In most hemolytic states , the hemolysis is predominantly extravascular ( in the reticuloendothelial system like liver & spleen)
Less coomonly red cell lysis occur within the blood stream , i.e. intravscular hh
causes of intravascular hh :
1. Transfusion reaction
2. PNH ( paroxysmal nocturnal hemoglobinuria)
3. Infections ( malaria , clost. Perfringes)
4.Mechanical : heart valves, DIC ) ….
Causes of extravascular hh :
1. hemoglobinopathy
2. Membrane defects
3. Autoimmune hh anemia.
Thank
UFor listening